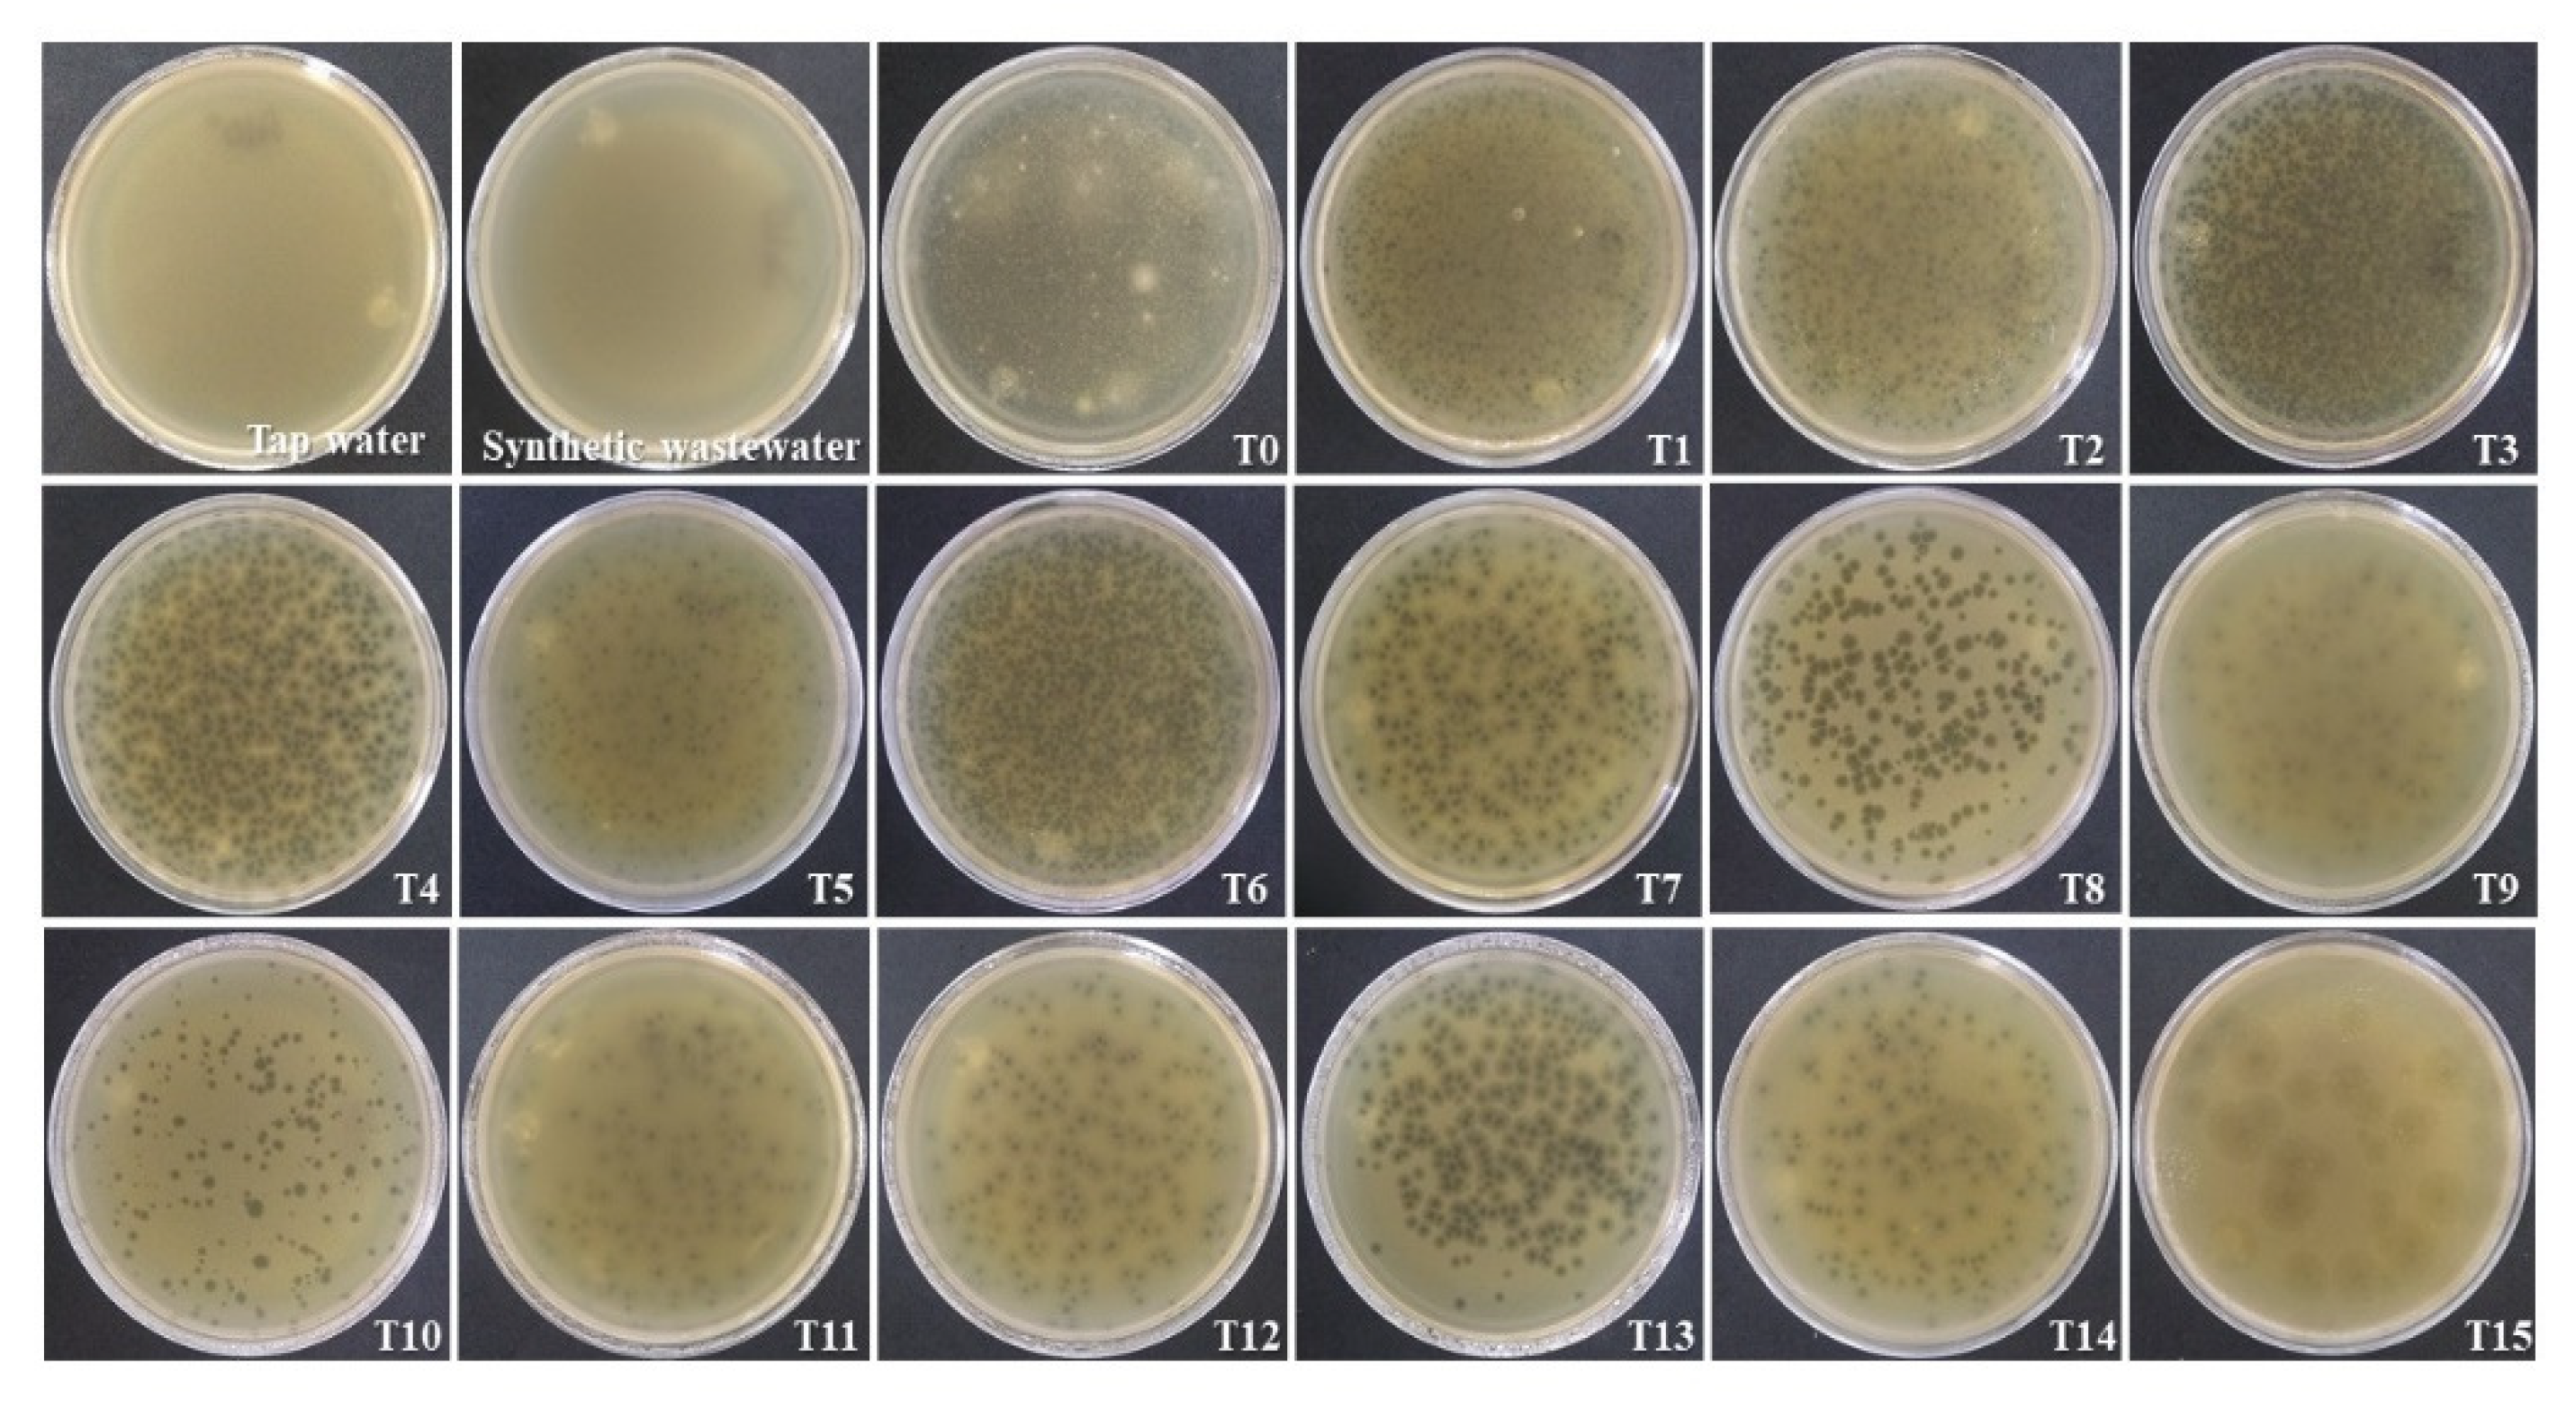
Water 13 02756 g003

Removal of Coliphage MS2 Using a Microbial Fuel Cell Stack
Abstract
:1. Introduction
2. Materials and Methods
2.1. Inoculum and Development of Halotolerant Microbial Bioanodes
2.2. Developing MFC Setup
2.3. Stack Assembly
2.4. Energy Storage Circuit
2.5. Analytical Methods
2.6. Electrochemical Measurements
2.7. Coliphage MS2 Propagation
2.8. Efficiency of Viral Load Removal in Bioelectrochemical Treatment System
3. Results
3.1. Evaluation of Physicochemical and Electrochemical Parameters
3.2. Coliphage MS2 Removal
4. Discussion
4.1. Evaluation of Physicochemical and Electrochemical Parameters
4.2. Coliphage MS2 Removal in Bioelectrochemical Treatment System
5. Conclusions
Author Contributions
Funding
Institutional Review Board Statement
Informed Consent Statement
Data Availability Statement
Acknowledgments
Conflicts of Interest
References
- Pasternak, G.; Greenman, J.; Ieropoulos, I. Removal of Hepatitis B virus surface HBsAg and core HBcAg antigens using microbial fuel cells producing electricity from human urine. Sci. Rep. 2019, 9, 11787. [Google Scholar] [CrossRef] [Green Version]
- Ieropoulos, I.; Pasternak, G.; Greenman, J. Urine disinfection and in situ pathogen killing using a Microbial Fuel Cell cascade system. PLoS ONE 2017, 12, e0176475. [Google Scholar] [CrossRef] [Green Version]
- Ieropoulos, I.A.; Stinchcombe, A.; Gajda, I.; Forbes, S.; Merino-Jimenez, I.; Pasternak, G.; Sanchez-Herranz, D.; Greenman, J. Pee power urinal–microbial fuel cell technology field trials in the context of sanitation. Environ. Sci. Water Res. Technol. 2016, 2, 336–343. [Google Scholar] [CrossRef] [Green Version]
- Naddeo, V.; Liu, H. Editorial Perspectives: 2019 novel coronavirus (SARS-CoV-2): What is its fate in urban water cycle and how can the water research community respond? Environ. Sci. Water Res. Technol. 2020, 6, 1213–1216. [Google Scholar] [CrossRef]
- Hung, H.C.; Chan, D.W.; Law, L.K.; Chan, E.H.; Wong, E.S. Industrial experience and research into the causes of SARS virus transmission in a high-rise residential housing estate in Hong Kong. Build. Serv. Eng. Res. Technol. 2006, 27, 91–102. [Google Scholar] [CrossRef]
- Wurtzer, S.; Waldman, P.; Ferrier-Rembert, A.; Frenois-Veyrat, G.; Mouchel, J.M.; Boni, M.; Madaye, Y.; OBEPINE consortium; Marecha, V.; Moulin, L. Several forms of SARS-CoV-2 RNA can be detected in wastewaters: Implication for wastewater-based epidemiology and risk assessment. Water Res. 2021, 198, 117183. [Google Scholar] [CrossRef]
- Al Huraimel, K.; Alhosani, M.; Kunhabdulla, S.; Stietiya, M.H. SARS-CoV-2 in the environment: Modes of transmission, early detection and potential role of pollutions. Sci. Total Environ. 2020, 744, 140946. [Google Scholar] [CrossRef] [PubMed]
- Científicos del CICY Detectan al SARS-CoV-2 en Aguas Residuales en Q. Roo. Available online: https://www.cicy.mx/noticias-y-eventos/boletin-08-cientificos-del-cicy-detectan-al-sars-cov-2-en-aguas-residuales-en-q-roo (accessed on 30 April 2021).
- Rosiles-González, G.; Carrillo-Jovel, V.H.; Alzate-Gaviria, L.; Betancourt, W.Q.; Gerba, C.P.; Moreno Valenzuela, O.; Tapia-Tussell, R.; Hernández-Zepeda, C. Environmental surveillance of SARS-CoV-2 RNA in wastewater and groundwater in Quintana Roo, Mexico. Food Environ. Virol. 2021. under review. [Google Scholar] [CrossRef]
- Atkins, J.F.; Steitz, J.A.; Anderson, C.W.; Model, P. Binding of mammalian ribosomes to MS2 phage RNA reveals an overlapping gene encoding a lysis function. Cell 1979, 18, 247–256. [Google Scholar] [CrossRef]
- Fiers, W.; Contreras, R.; Duerinck, F.; Haegeman, G.; Iserentant, D.; Merregaert, J.; Min Jou, W.; Molemans, F.; Raeymaekers, A.; Van den Berghe, A.; et al. Complete nucleotide sequence of bacteriophage MS2 RNA: Primary and secondary structure of the replicase gene. Nature 1976, 260, 500–507. [Google Scholar] [CrossRef] [PubMed]
- Tapia-Tussell, R.; Valle-Gough, R.E.; Peraza-Baeza, I.; Domínguez-Maldonado, J.; Gonzalez-Muñoz, M.; Cortes-Velazquez, A.; Leal-Baustista, R.; Alzate-Gaviria, L. Influence of two polarization potentials on a bioanode microbial community isolated from a hypersaline coastal lagoon of the Yucatan peninsula, in México. Sci. Total Environ. 2019, 681, 258–266. [Google Scholar] [CrossRef]
- Ghasemi, M.; Daud, W.R.W.; Ismail, A.F.; Jafari, Y.; Ismail, M.; Mayahi, A.; Othman, J. Simultaneous wastewater treatment and electricity generation by microbial fuel cell: Performance comparison and cost investigation of using Nafion 117 and SPEEK as separators. Desalination 2013, 325, 1–6. [Google Scholar] [CrossRef]
- Nandy, A.; Kumar, V.; Mondal, S.; Dutta, K.; Salah, M.; Kundu, P.P. Performance evaluation of microbial fuel cells: Effect of varying electrode configuration and presence of a membrane electrode assembly. New Biotechnol. 2015, 32, 272–281. [Google Scholar] [CrossRef] [PubMed]
- Atkinson III, R.W.; Hazard, M.W.; Rodgers, J.A.; Stroman, R.O.; Gould, B.D. An open-cathode fuel cell for atmospheric flight. J. Electrochem. Soc. 2016, 164, F46. [Google Scholar] [CrossRef]
- Valladares Linares, R.; Domínguez-Maldonado, J.; Rodríguez-Leal, E.; Patrón, G.; Castillo-Hernández, A.; Miranda, A.; Díaz Romero, D.; Moreno-Cervera, R.; Cámara-chale, G.; Borroto, C.G.; et al. Scale up of microbial fuel cell stack system for residential wastewater treatment in continuous mode operation. Water 2019, 11, 217. [Google Scholar] [CrossRef] [Green Version]
- Alzate-Gaviria, L.M.; Dominguez-Maldonado, J.A.; Del Rio-Rivera, F.J.; Flota-Banuelos, M.I.; Camara-Chale, G.R. Electronic circuit for harvesting energy from ultra-low power sources. U.S. Patent Application No. 15/752,830, 4 August 2020. [Google Scholar]
- Water Environmental Federation; American Public Health Association (APHA). Standard Methods for the Examination of Water and Wastewater; American Public Health Association: Washington, DC, USA, 2005. [Google Scholar]
- Pind, P.F.; Angelidaki, I.; Ahring, B.K. A new VFA sensor technique for anaerobic reactor systems. Biotechnol. Bioeng. 2003, 82, 54–61. [Google Scholar] [CrossRef]
- Shimoyama, T.; Komukai, S.; Yamazawa, A.; Ueno, Y.; Logan, B.E.; Watanabe, K. Electricity generation from model organic wastewater in a cassette-electrode microbial fuel cell. Appl. Microbiol. Biotechnol. 2008, 80, 325–330. [Google Scholar] [CrossRef] [PubMed]
- Monasterio, S.; Mascia, M.; Di Lorenzo, M. Electrochemical removal of microalgae with an integrated electrolysis-microbial fuel cell closed-loop system. Sep. Purif. Technol. 2017, 183, 373–381. [Google Scholar] [CrossRef]
- Erable, B.; Etcheverry, L.; Bergel, A. From microbial fuel cell (MFC) to microbial electrochemical snorkel (MES): Maximizing chemical oxygen demand (COD) removal from wastewater. Biofouling 2011, 27, 319–326. [Google Scholar] [CrossRef] [PubMed] [Green Version]
- Rashid, T.; Sher, F.; Hazafa, A.; Hashmi, R.Q.; Zafar, A.; Rasheed, T.; Hussain, S. Design and feasibility study of novel paraboloid graphite based microbial fuel cell for bioelectrogenesis and pharmaceutical wastewater treatment. J. Environ. Chem. Eng. 2021, 9, 104502. [Google Scholar] [CrossRef]
- Kim, K.Y.; Chae, K.J.; Choi, M.J.; Yang, E.T.; Hwang, M.H.; Kim, I.S. High-quality effluent and electricity production from non-CEM based flow-through type microbial fuel cell. Chem. Eng. J. 2013, 218, 19–23. [Google Scholar] [CrossRef]
- Yang, G.; Wang, J.; Zhang, H.; Jia, H.; Zhang, Y.; Cui, Z.; Gao, F. Maximizing energy recovery from homeostasis in microbial fuel cell by synergistic conversion of short-chain volatile fatty acid. Bioresour. Technol. Rep. 2019, 7, 100200. [Google Scholar] [CrossRef]
- Indarto, A.; Ikhsan, N.A.; Wibowo, I. Applications of carbon nanotubes for controlling waterborne pathogens. Waterborne Pathog. 2020, 433–461. [Google Scholar] [CrossRef]
- Gupta, R.; Bekele, W.; Ghatak, A. Harvesting energy of interaction between bacteria and bacteriophage in a membrane-less fuel cell. Bioresour. Technol. 2013, 147, 654–657. [Google Scholar] [CrossRef] [PubMed]
- Santhanam, K.S. Electrochemical approaches towards sensing viruses: A mini review. Med. Devices Sensors 2021, 4, e10148. [Google Scholar]
- Smith, S.C.; Rodrigues, D.F. Carbon-based nanomaterials for removal of chemical and biological contaminants from water: A review of mechanisms and applications. Carbon 2015, 91, 122–143. [Google Scholar] [CrossRef]

| Time after Coliphage MS2 Inoculation (Hours) | Initial Concentration (Ci; PFU/mL) | Final Concentration (Cf; PFU/mL) | Logarithmic Reduction Value (LRV) | Efficiency Percentage (%) |
|---|---|---|---|---|
| 1 | 6.89 × 107 | 8000 | 3.94 | 99.9884 |
| 2 | 6.89 × 107 | 7040 | 3.99 | 99.9898 |
| 3 | 6.89 × 107 | 9380 | 3.87 | 99.9864 |
| 4 | 6.89 × 107 | 4635 | 4.17 | 99.9933 |
| 5 | 6.89 × 107 | 3280 | 4.32 | 99.9952 |
| 6 | 6.89 × 107 | 3000 | 4.36 | 99.9956 |
| 8 | 6.89 × 107 | 2395 | 4.46 | 99.9965 |
| 9 | 6.89 × 107 | 430 | 5.20 | 99.9994 |
| 10 | 6.89 × 107 | 1140 | 4.78 | 99.9983 |
| 11 | 6.89 × 107 | 985 | 4.84 | 99.9986 |
| 12 | 6.89 × 107 | 1400 | 4.69 | 99.9980 |
| 13 | 6.89 × 107 | 1855 | 4.57 | 99.9973 |
| 14 | 6.89 × 107 | 1180 | 4.77 | 99.9983 |
| 15 | 6.89 × 107 | 285 | 5.38 | 99.9996 |
Publisher’s Note: MDPI stays neutral with regard to jurisdictional claims in published maps and institutional affiliations. |
© 2021 by the authors. Licensee MDPI, Basel, Switzerland. This article is an open access article distributed under the terms and conditions of the Creative Commons Attribution (CC BY) license (https://creativecommons.org/licenses/by/4.0/).
Share and Cite
Alzate-Gaviria, L.; Tapia-Tussell, R.; Domínguez-Maldonado, J.; Chable-Villacis, R.; Rosiles González, G.; Hernández-Zepeda, C. Removal of Coliphage MS2 Using a Microbial Fuel Cell Stack. Water 2021, 13, 2756. https://doi.org/10.3390/w13192756
Alzate-Gaviria L, Tapia-Tussell R, Domínguez-Maldonado J, Chable-Villacis R, Rosiles González G, Hernández-Zepeda C. Removal of Coliphage MS2 Using a Microbial Fuel Cell Stack. Water. 2021; 13(19):2756. https://doi.org/10.3390/w13192756
Chicago/Turabian StyleAlzate-Gaviria, Liliana, Raul Tapia-Tussell, Jorge Domínguez-Maldonado, Rubi Chable-Villacis, Gabriela Rosiles González, and Cecilia Hernández-Zepeda. 2021. "Removal of Coliphage MS2 Using a Microbial Fuel Cell Stack" Water 13, no. 19: 2756. https://doi.org/10.3390/w13192756
APA StyleAlzate-Gaviria, L., Tapia-Tussell, R., Domínguez-Maldonado, J., Chable-Villacis, R., Rosiles González, G., & Hernández-Zepeda, C. (2021). Removal of Coliphage MS2 Using a Microbial Fuel Cell Stack. Water, 13(19), 2756. https://doi.org/10.3390/w13192756

